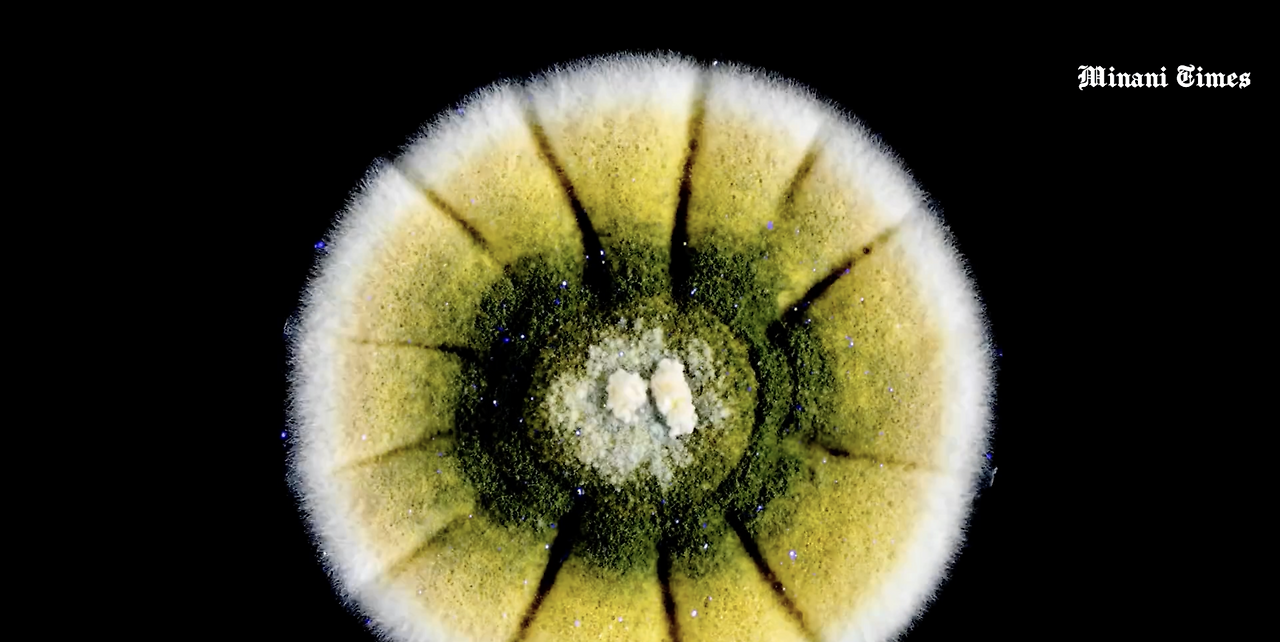
스크린샷 2023-03-12 오후 6.20.18.png

기존 식물과 버섯 연구는 잘못 되었다..?
다시 시작된 논란..
인간과 동물들만이 소통을 하는 것은 아닐 겁니다.
식물과 균류도 서로 소통하는 현상들이 관찰되었거든요. 지금까진 지능이 없어서 식물과 균류가 소통하지 못한다고 생각했지만, 그저 우리와 다르게 소통하는 것뿐입니다. 소리가 아닌 다른 것으로요.
(토끼와 일부 포유류는 소변과 대변으로 소통한다.)
 과학 커뮤니케이터 지식인 미나니
과학 커뮤니케이터 지식인 미나니식물학자 미생물학자 생물학자분들은 과거부터 계속해서 식물들이 서로 어떻게 소통하는지 연구해왔습니다. 그리고 아주 많은 것들을 알게 되었죠.
식물이 벌레들에게 공격 당할 때 눈에 보이지 않는 화학물질을 뿜어내어 주변 식물들에게 알리고 방어 물질을 내뿜게 합니다.
또 어린 옥수수나 일부 식물은 뿌리에서 딸각 소리도 냅니다. 물론 우리는 들리지 않죠.
그중 가장 유명해진 이론은 브리티시컬럼비아 대학교 생태학자인 수잔 시마드님(Suzanne Simard)께서 발표한 내용입니다.

나무와 나무는 지하 흙 속에서 인터넷 케이블처럼 연결되어 서로 소통한다는 것! 그리고 그 소통을 돕는 것은 바로 곰팡이들! 지구상의 모든 곰팡이 종 중 90%가 땅속에서 생활하고 있습니다.
이 곰팡이들은 마치 거미줄처럼 서로 엉키고 엉켜 최대 10km에 달하는 거대한 네트워크를 형성합니다. 그리고 이걸 균사체라 부르죠. 또 일부 균사체는 조건이 맞을 때 버섯으로 피어오릅니다.
균근이라 불리는 이 곰팡이들은 나무뿌리 주변에 살아가면서 나무가 필요로 하는 질소를 제공하는 대가로 나무가 보내주는 당분을 얻어먹기도 하지만 여러 나무뿌리 사이를 연결하면서 A라는 나무가 광합성을 제대로 하지 못해 영양분이 부족할 때 B라는 나무가 균근을 통해 A 나무에 당분을 보내 주는 것도 확인했습니다.
또한 오래되고 큰 나무가 주변에 자라나고 있는 어린 나무에 균근을 통해 수분이나 영양분을 주는 것도 확인했습니다.
 균근 네트워크
균근 네트워크어떻게 알아냈느냐! 실험 방식은 나무에 추적이 쉬운 방사성동위원소가 담긴 물을 주사기로 넣고 방사선 측정기로 방사성 물이 나무줄기 속 관과 뿌리를 지나서 주변 묘목에서도 측정되는 것을 관찰했습니다. 그리고 이동하는 것을 확인했습니다.


하지만 최근 시마드의 연구가 조금은 많이 과장되었다는 연구들이 하나둘씩 나오고 있습니다.
캐나다 앨버타 대학교 카스트, 존스 연구원 그리고 미시시피 대학의 제이슨 연구원은 나무와 곰팡이 사이의 관계가 있기는 하지만 몇몇 추가 실험에서 시마드의 연구 결과 일부가 별로 의미 없었다는 결과를 발표했습니다.



우선 흙 속의 곰팡이들의 네트워크, 다르게 말해서 균근 네트워크를 연구하기 위해 땅을 파는 순간 네트워크가 무너져서 야외에서 제대로 연구가 진행되지 않는다는 점.
또 크고 오래된 나무가 어린 묘목에게 영양분을 제공해 준다는 이론을 재현하기 위해 통제된 실험실 환경에서 실험 해보니 실제로 묘목이 잘 자라게 된 비율이 20% 미만이라는 점.
(나머지 80% 이상은 효과 없거나 오히려 잘 못자람)
등이었습니다.
곰팡이 균사체
곰팡이 균사체그렇다고 이들이 균근 네트워크 역할 자체가 뻥이라고는 하지 않았습니다. 나무와 나무 사이를 연결해 주는 일부 역할을 하고 있을 것이라 생각하고 있지만 아직 연구들이 부족해 확신할 수 없다는 것입니다.
과학은 끊임없이 진화하는 분야입니다. 이론이 제안되고, 테스트되고, 수정되는 과정을 반복하면서 진실에 더 가까이 다가갈 수 있습니다.
자연의 신비를 계속 탐구할 때, 어떤 이론도 확정된 것은 없다는 사실을 기억하는 것이 중요합니다. 새로운 증거는 언제나 등장할 수 있으며, 이를 통해 자연계에 대한 우리의 이해를 재평가하고 개선할 수 있습니다.
참고자료
-'‘Mother Trees’ Are Intelligent: They Learn and Remember', scientificamerican, By Richard Schiffman
-'Do Trees Really Support Each Other through a Network of Fungi?',scientificamerican,By Stephanie Pappas
-Simard, S., Perry, D., Jones, M. et al. Net transfer of carbon between ectomycorrhizal tree species in the field. Nature 388, 579–582 (1997). https://doi.org/10.1038/41557
-Francis, R., Read, D. Direct transfer of carbon between plants connected by vesicular–arbuscular mycorrhizal mycelium. Nature 307, 53–56 (1984). https://doi.org/10.1038/307053a0
-How Do Trees Collaborate?, TED,January 13, 2017.
-책 ‘숲은 고요하지 않다. 흐름출판, 마들렌 치게 저
-'Scientists tangle over ‘wood wide web’ connecting forests and fungi', washingtonpost,By Sarah Kaplan
-Pickles BJ, Wilhelm R, Asay AK, Hahn AS, Simard SW, Mohn WW. Transfer of 13 C between paired Douglas-fir seedlings reveals plant kinship effects and uptake of exudates by ectomycorrhizas. New Phytol. 2017 Apr;214(1):400-411. doi: 10.1111/nph.14325. Epub 2016 Nov 21. PMID: 27870059.
-Karst, J., Jones, M.D. & Hoeksema, J.D. Positive citation bias and overinterpreted results lead to misinformation on common mycorrhizal networks in forests. Nat Ecol Evol (2023). https://doi.org/10.1038/s41559-023-01986-1